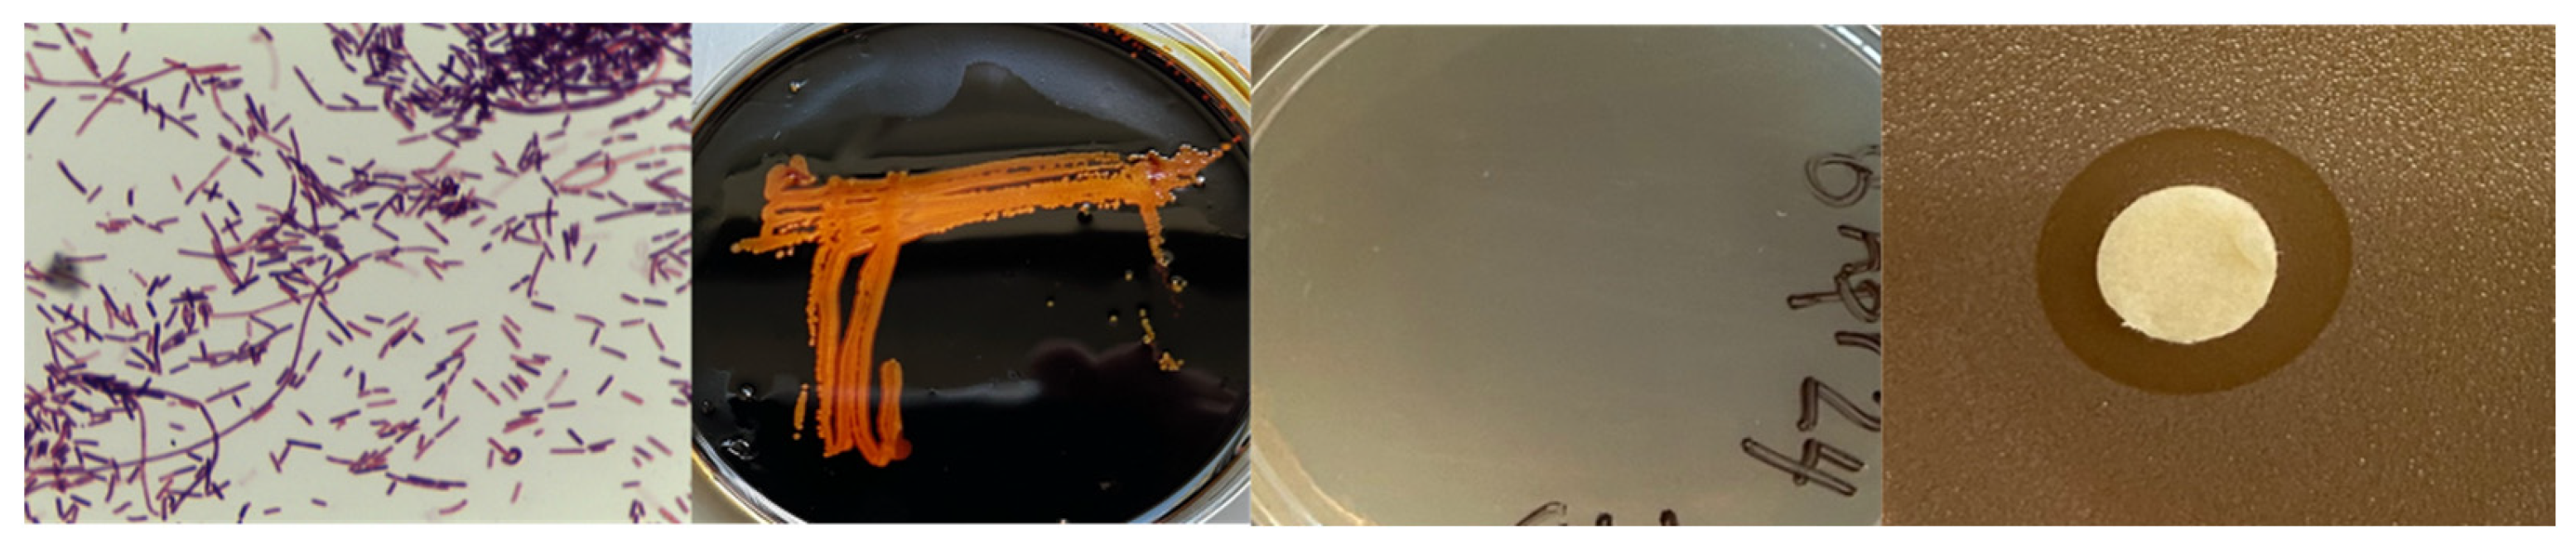
Vetsci 12 00051 g001

Phenotypic and Complete Reference Whole Genome Sequence Analyses of Two Paenibacillus spp. Isolates from a Gray Wolf (Canis lupus) Gastrointestinal Tract
Simple Summary
Abstract
1. Introduction
2. Materials and Methods
2.1. Isolation of Bacteria, Phenotypic Characterization and Bacterial Growth Inhibition
2.2. Bacterial Genomic DNA Isolation and Whole Genome Sequencing Analyses of Bacteria
2.3. Phylogenetic Analyses of the Wolf Bacterial Isolates
3. Results
3.1. Isolation of Bacteria from a Gray Wolf Gastrointestinal Tract, Phenotypic Characteristics and Growth Inhibition of Target Bacteria
3.2. Whole Genome Sequence of Gray Wolf Bacterial Isolates
3.3. Phylogenetic Analyses of Isolates of Gray Wolf Bacterial Isolates
4. Discussion
5. Conclusions
Supplementary Materials
Author Contributions
Funding
Institutional Review Board Statement
Informed Consent Statement
Data Availability Statement
Acknowledgments
Conflicts of Interest
References
- Vázquez-Baeza, Y.; Hyde, E.R.; Suchodolski, J.S.; Knight, R. Dog and human inflammatory bowel disease rely on overlapping yet distinct dysbiosis networks. Nat. Microbiol. 2016, 1, 16177. [Google Scholar] [CrossRef]
- Jergens, A.E.; Heilmann, R.M. Canine chronic enteropathy-Current state-of-the-art and emerging concepts. Front. Vet. Sci. 2022, 9, 923013. [Google Scholar] [CrossRef] [PubMed]
- Rhimi, S.; Kriaa, A.; Mariaule, V.; Saidi, A.; Drut, A.; Jablaoui, A.; Akermi, N.; Maguin, E.; Hernandez, J.; Rhimi, M. The Nexus of Diet, Gut Microbiota and Inflammatory Bowel Diseases in Dogs. Metabolites 2022, 12, 1176. [Google Scholar] [CrossRef] [PubMed]
- Doulidis, P.G.; Galler, A.I.; Hausmann, B.; Berry, D.; Rodríguez-Rojas, A.; Burgener, I.A. Gut microbiome signatures of Yorkshire Terrier enteropathy during disease and remission. Sci. Rep. 2023, 13, 4337. [Google Scholar] [CrossRef]
- Kathrani, A.; Werling, D.; Allenspach, K. Canine Breeds at High Risk of Developing Inflammatory Bowel Disease in the South-Eastern UK. Vet. Rec. 2011, 169, 635. [Google Scholar] [CrossRef]
- Pilla, R.; Suchodolski, J.S. The Gut Microbiome of Dogs and Cats, and the Influence of Diet. Vet. Clin. North Am. Small Anim. Pract. 2021, 51, 605–621. [Google Scholar] [CrossRef]
- Bergström, A.; Stanton, D.W.G.; Taron, U.H.; Frantz, L.; Sinding, M.S.; Ersmark, E.; Pfrengle, S.; Cassatt-Johnstone, M.; Lebrasseur, O.; Girdland-Flink, L.; et al. Grey wolf genomic history reveals a dual ancestry of dogs. Nature 2022, 607, 313–320. [Google Scholar] [CrossRef]
- Meadows, J.R.S.; Kidd, J.M.; Wang, G.D.; Parker, H.G.; Schall, P.Z.; Bianchi, M.; Christmas, M.J.; Bougiouri, K.; Buckley, R.M.; Hitte, C.; et al. Genome sequencing of 2000 canids by the Dog10K consortium advances the understanding of demography, genome function and architecture. Genome Biol. 2023, 24, 187, Erratum in Genome Biol. 2023, 24, https://doi.org/10.1186/s13059-023-03101-w. [Google Scholar] [CrossRef]
- Perri, A.R.; Feuerborn, T.R.; Frantz, L.A.F.; Larson, G.; Malhi, R.S.; Meltzer, D.J.; Witt, K.E. Dog domestication and the dual dispersal of people and dogs into the Americas. Proc. Natl. Acad. Sci. USA 2021, 118, e2010083118. [Google Scholar] [CrossRef]
- Feuerborn, T.R.; Carmagnini, A.; Losey, R.J.; Nomokonova, T.; Askeyev, A.; Askeyev, I.; Askeyev, O.; Antipina, E.E.; Appelt, M.; Bachura, O.P.; et al. Modern Siberian dog ancestry was shaped by several thousand years of Eurasian-wide trade and human dispersal. Proc. Natl. Acad. Sci. USA 2021, 118, e2100338118. [Google Scholar] [CrossRef]
- Tancredi, D.; Cardinali, I. Being a Dog: A Review of the Domestication Process. Genes 2023, 14, 992. [Google Scholar] [CrossRef] [PubMed]
- Halfvarson, J.; Brislawn, C.J.; Lamendella, R.; Vázquez-Baeza, Y.; Walters, W.A.; Bramer, L.M.; D’Amato, M.; Bonfiglio, F.; McDonald, D.; Gonzalez, A.; et al. Dynamics of the human gut microbiome in inflammatory bowel disease. Nat. Microbiol. 2017, 2, 17004. [Google Scholar] [CrossRef]
- Moeller, A.H.; Sanders, J.G. Roles of the gut microbiota in the adaptive evolution of mammalian species. Philos. Trans. R. Soc. Lond. B Biol. Sci. 2020, 375, 20190597. [Google Scholar] [CrossRef]
- Dillard, B.A.; Chung, A.K.; Gunderson, A.R.; Campbell-Staton, S.C.; Moeller, A.H. Humanization of wildlife gut microbiota in urban environments. eLife 2022, 11, e76381. [Google Scholar] [CrossRef]
- Arendt, M.; Cairns, K.M.; Ballard, J.W.; Savolainen, P.; Axelsson, E. Diet adaptation in dog reflects spread of prehistoric agriculture. Heredity 2016, 117, 301–306. [Google Scholar] [CrossRef]
- Corsato Alvarenga, I.; Aldrich, C.G. Starch characterization of commercial extruded dry pet foods. Transl. Anim. Sci. 2020, 4, txaa018. [Google Scholar] [CrossRef]
- Richards, T.L.; Rankovic, A.; Cant, J.P.; Shoveller, A.K.; Adolphe, J.L.; Ramdath, D.; Verbrugghe, A. Effect of Total Starch and Resistant Starch in Commercial Extruded Dog Foods on Gastric Emptying in Siberian Huskies. Animals 2021, 11, 2928. [Google Scholar] [CrossRef]
- Yang, Q.; Wu, Z. Gut Probiotics and Health of Dogs and Cats: Benefits, Applications, and Underlying Mechanisms. Microorganisms 2023, 11, 2452. [Google Scholar] [CrossRef]
- Salminen, S.; Collado, M.C.; Endo, A.; Hill, C.; Lebeer, S.; Quigley, E.M.M.; Sanders, M.E.; Shamir, R.; Swann, J.R.; Szajewska, H.; et al. The International Scientific Association of Probiotics and Prebiotics (ISAPP) consensus statement on the definition and scope of postbiotics. Nat. Rev. Gastroenterol. Hepatol. 2021, 18, 649–667, Erratum in Nat. Rev. Gastroenterol. Hepatol. 2021, 18, 671; Erratum in Nat. Rev. Gastroenterol. Hepatol. 2022, 19, 551. [Google Scholar] [CrossRef]
- Schmitz, S.S. Value of Probiotics in Canine and Feline Gastroenterology. Vet. Clin. N. Am. Small Anim. Pract. 2021, 51, 171–217. [Google Scholar] [CrossRef]
- Lee, D.; Goh, T.W.; Kang, M.G.; Choi, H.J.; Yeo, S.Y.; Yang, J.; Huh, C.S.; Kim, Y.Y.; Kim, Y. Perspectives and advances in probiotics and the gut microbiome in companion animals. J. Anim. Sci. Technol. 2022, 64, 197–217. [Google Scholar] [CrossRef] [PubMed]
- Miller, E.A.; Amato, R.; Ponder, J.B.; Bueno, I. Survey of antimicrobial and probiotic use practices in wildlife rehabilitation in the United States. PLoS ONE 2024, 19, e0308261. [Google Scholar] [CrossRef] [PubMed]
- Ash, C.; Priest, F.G.; Collins, M.D. Molecular identification of rRNA group 3 bacilli (Ash, Farrow, Wallbanks and Collins) using a PCR probe test. Proposal for the creation of a new genus Paenibacillus. Antonie Van Leeuwenhoek 1993, 64, 253–260. [Google Scholar] [CrossRef] [PubMed]
- Information, A. Validation of the Publication of New Names and New Combinations Previously Effectively Published Outside the IJSB: List No. 51. Int. J. Syst. Bacteriol. 1994, 44, 852. [Google Scholar] [CrossRef][Green Version]
- Grady, E.N.; MacDonald, J.; Liu, L.; Richman, A.; Yuan, Z.C. Current knowledge and perspectives of Paenibacillus: A review. Microb. Cell Factories 2016, 15, 203. [Google Scholar] [CrossRef] [PubMed] [PubMed Central]
- Plouhinec, L.; Neugnot, V.; Lafond, M.; Berrin, J.G. Carbohydrate-active enzymes in animal feed. Biotechnol. Adv. 2023, 65, 108145. [Google Scholar] [CrossRef] [PubMed]
- Sureshkumar, S.; Song, J.; Sampath, V.; Kim, I. Exogenous Enzymes as Zootechnical Additives in Monogastric Animal Feed: A Review. Agriculture 2023, 13, 2195. [Google Scholar] [CrossRef]
- McCabe, J.; Bryant, J.L.; Klews, C.C.; Johnson, M.; Atchley, A.N.; Cousins, T.W.; Dominguez, A.; Gabriel, M.; Middleton, K.; Bowles, N.A.; et al. Phenotypic and Draft Genome Sequence Analyses of a Paenibacillus sp. isolated from the Gastrointestinal Tract of a North American Gray Wolf (Canis lupus). Appl. Microbiol. 2023, 3, 1120–1129. [Google Scholar] [CrossRef]
- Atarashi, K.; Tanoue, T.; Shima, T.; Imaoka, A.; Kuwahara, T.; Momose, Y.; Cheng, G.; Yamasaki, S.; Saito, T.; Ohba, Y.; et al. Induction of colonic regulatory T cells by indigenous Clostridium species. Science 2011, 331, 337–341. [Google Scholar] [CrossRef]
- Chapin, K.; Murray, P. Manual of Clinical Microbiology, 7th ed.; Murray, P.R., Baron, E.J., Pfaller, M.A., Tenover, F.C., Yolken, R.H., Eds.; American Society for Microbiology: Washington, DC, USA, 1999. [Google Scholar]
- Mahon, C.R.; Lehman, D.C.; Manuselis, G. Textbook of Diagnostic Microbiology, 5th ed.; W. B Saunders Co.: Philadelphia, PA, USA, 2014. [Google Scholar]
- CLSI. Performance Standards for Antimicrobial Susceptibility Testing M100, 32nd ed.; Clinical and Laboratory Standards Institute: Wayne, PA, USA, 2022. [Google Scholar]
- Hardy, B.L.; Bansal, G.; Hewlett, K.H.; Arora, A.; Schaffer, S.D.; Kamau, E.; Bennett, J.W.; Merrell, D.S. Antimicrobial Activity of Clinically Isolated Bacterial Species Against Staphylococcus aureus. Front. Microbiol. 2020, 10, 2977. [Google Scholar] [CrossRef]
- Kolmogorov, M.; Yuan, J.; Lin, Y.; Pevzner, P.A. Assembly of long, error-prone reads using repeat graphs. Nat. Biotechnol. 2019, 37, 540–546. [Google Scholar] [CrossRef] [PubMed]
- Li, H. Toward a better understanding of artifacts in variant calling from high-coverage samples. Bioinformatics 2014, 30, 2843–2851. [Google Scholar] [CrossRef] [PubMed]
- Wick, R.R.; Holt, K.E. Polypolish: Short-read polishing of long-read bacterial genome assemblies. PLoS Comput. Biol. 2022, 18, e1009802. [Google Scholar] [CrossRef] [PubMed]
- Parks, D.H.; Imelfort, M.; Skennerton, C.T.; Hugenholtz, P.; Tyson, G.W. CheckM: Assessing the quality of microbial genomes recovered from isolates, single cells, and metagenomes. Genome Res. 2015, 25, 1043–1055. [Google Scholar] [CrossRef]
- Seemann, T. Prokka: Rapid prokaryotic genome annotation. Bioinformatics 2014, 30, 2068–2069. [Google Scholar] [CrossRef]
- Cumsille, A.; Durán, R.E.; Rodríguez-Delherbe, A.; Saona-Urmeneta, V.; Cámara, B.; Seeger, M.; Araya, M.; Jara, N.; Buil-Aranda, C. GenoVi, an open-source automated circular genome visualizer for bacteria and archaea. PLoS Comput. Biol. 2023, 19, e1010998. [Google Scholar] [CrossRef]
- Kim, J.; Na, S.I.; Kim, D.; Chun, J. UBCG2: Up-to-date bacterial core genes and pipeline for phylogenomic analysis. J. Microbiol. 2021, 59, 609–615. [Google Scholar] [CrossRef]
- Chalita, M.; Kim, Y.O.; Park, S.; Oh, H.S.; Cho, J.H.; Moon, J.; Baek, N.; Moon, C.; Lee, K.; Yang, J.; et al. EzBioCloud: A genome-driven database and platform for microbiome identification and discovery. Int. J. Syst. Evol. Microbiol. 2024, 74, 006421. [Google Scholar] [CrossRef]
- Katoh, K.; Standley, D.M. MAFFT multiple sequence alignment software version 7: Improvements in performance and usability. Mol. Biol. Evol. 2013, 30, 772–780. [Google Scholar] [CrossRef]
- Kozlov, A.M.; Darriba, D.; Flouri, T.; Morel, B.; Stamatakis, A. RAxML-NG: A fast, scalable and user-friendly tool for maximum likelihood phylogenetic inference. Bioinformatics 2019, 35, 4453–4455. [Google Scholar] [CrossRef]
- Langmead, B.; Salzberg, S.L. Fast gapped-read alignment with Bowtie 2. Nat. Methods 2012, 9, 357–359. [Google Scholar] [CrossRef] [PubMed]
- Li, H.; Handsaker, B.; Wysoker, A.; Fennell, T.; Ruan, J.; Homer, N.; Marth, G.; Abecasis, G.; Durbin, R. 1000 Genome Project Data Processing Subgroup. The Sequence Alignment/Map format and SAMtools. Bioinformatics 2009, 25, 2078–2079. [Google Scholar] [CrossRef] [PubMed]
- Liu, B.; Zheng, D.; Jin, Q.; Chen, L.; Yang, J. VFDB 2019: A comparative pathogenomic platform with an interactive web interface. Nucleic Acids Res. 2019, 47, D687–D692. [Google Scholar] [CrossRef] [PubMed]
- Yoon, S.H.; Ha, S.M.; Kwon, S.; Lim, J.; Kim, Y.; Seo, H.; Chun, J. Introducing EzBioCloud: A taxonomically united database of 16S rRNA gene sequences and whole-genome assemblies. Int. J. Syst. Evol. Microbiol. 2017, 67, 1613–1617. [Google Scholar] [CrossRef]
- Yoon, S.H.; Ha, S.M.; Lim, J.; Kwon, S.; Chun, J. A large-scale evaluation of algorithms to calculate average nucleotide identity. Antonie Van Leeuwenhoek 2017, 110, 1281–1286. [Google Scholar] [CrossRef]
- Paradis, E.; Schliep, K. ape 5.0: An environment for modern phylogenetics and evolutionary analyses in R. Bioinformatics 2019, 35, 526–528. [Google Scholar] [CrossRef]
- Treangen, T.J.; Ondov, B.D.; Koren, S.; Phillippy, A.M. The Harvest suite for rapid core-genome alignment and visualization of thousands of intraspecific microbial genomes. Genome Biol. 2014, 15, 524. [Google Scholar] [CrossRef]
- Meier-Kolthoff, J.P.; Carbasse, J.S.; Peinado-Olarte, R.L.; Göker, M. TYGS and LPSN: A database tandem for fast and reliable genome-based classification and nomenclature of prokaryotes. Nucleic Acids Res. 2022, 7, D801–D807. [Google Scholar] [CrossRef]
- Kumar, S.; Stecher, G.; Suleski, M.; Sanderford, M.; Sharma, S.; Tamura, K. MEGA12: Molecular Evolutionary Genetic Analysis version 12 for adaptive and green computing. Mol. Biol. Evol. 2024, 41, msae263. [Google Scholar] [CrossRef]
- Blin, K.; Shaw, S.; Medema, M.H.; Weber, T. The antiSMASH database version 4: Additional genomes and BGCs, new sequence-based searches and more. Nucleic Acids Res. 2024, 52, D586–D589. [Google Scholar] [CrossRef]
- Wishart, D.S.; Han, S.; Saha, S.; Oler, E.; Peters, H.; Grant, J.R.; Stothard, P.; Gautam, V. PHASTEST: Faster than PHASTER, better than PHAST. Nucleic Acids Res. 2023, 51, W443–W450. [Google Scholar] [CrossRef] [PubMed]
- Ero, R.; Yan, X.F.; Gao, Y.G. Ribosome Protection Proteins-”New” Players in the Global Arms Race with Antibiotic-Resistant Pathogens. Int. J. Mol. Sci. 2021, 22, 5356. [Google Scholar] [CrossRef] [PubMed]
- Trimble, M.J.; Mlynárčik, P.; Kolář, M.; Hancock, R.E. Polymyxin: Alternative Mechanisms of Action and Resistance. Cold Spring Harb. Perspect. Med. 2016, 6, a025288. [Google Scholar] [CrossRef] [PubMed]
- Slingerland, C.J.; Martin, N.I. Recent Advances in the Development of Polymyxin Antibiotics: 2010–2023. ACS Infect. Dis. 2024, 10, 1056–1079. [Google Scholar] [CrossRef] [PubMed]
- Baindara, P.; Nayudu, N.; Korpole, S. Whole genome mining reveals a diverse repertoire of lanthionine synthetases and lanthipeptides among the genus Paenibacillus. J. Appl. Microbiol. 2020, 128, 473–490. [Google Scholar] [CrossRef]
- Cheng, C.; Hua, Z.C. Lasso Peptides: Heterologous Production and Potential Medical Application. Front. Bioeng. Biotechnol. 2020, 8, 571165. [Google Scholar] [CrossRef]
- Barrett, S.E.; Mitchell, D.A. Advances in lasso peptide discovery, biosynthesis, and function. Trends Genet. 2024, 40, 950–968. [Google Scholar] [CrossRef]
- Sirota-Madi, A.; Olender, T.; Helman, Y.; Brainis, I.; Finkelshtein, A.; Roth, D.; Hagai, E.; Leshkowitz, D.; Brodsky, L.; Galatenko, V.; et al. Genome sequence of the pattern-forming social bacterium Paenibacillus dendritiformis C454 chiral morphotype. J. Bacteriol. 2012, 194, 2127–2128. [Google Scholar] [CrossRef]
- Zhu, S.; Hegemann, J.D.; Fage, C.D.; Zimmermann, M.; Xie, X.; Linne, U.; Marahiel, M.A. Insights into the Unique Phosphorylation of the Lasso Peptide Paeninodin. J. Biol. Chem. 2016, 291, 13662–13678. [Google Scholar] [CrossRef]
- Kumar, M.; Chakdar, H.; Pandiyan, K.; Thapa, S.; Shahid, M.; Singh, A.; Srivastava, A.K.; Saxena, A.K. Bacterial chitinases: Genetics, engineering and applications. World J. Microbiol. Biotechnol. 2022, 38, 252. [Google Scholar] [CrossRef]
- Wu, L.; Luo, Y. Bacterial quorum-sensing systems and their role in intestinal bacteria-host crosstalk. Front. Microbiol. 2021, 12, 611413. [Google Scholar] [CrossRef] [PubMed]
- Piewngam, P.; Zheng, Y.; Nguyen, T.H.; Dickey, S.W.; Joo, H.S.; Villaruz, A.E.; Glose, K.A.; Fisher, E.L.; Hunt, R.L.; Li, B.; et al. Pathogen elimination by probiotic Bacillus via signalling interference. Nature 2018, 562, 532–537. [Google Scholar] [CrossRef] [PubMed]
- Li, E.; Liu, K.; Yang, S.; Li, L.; Ran, K.; Sun, X.; Qu, J.; Zhao, L.; Xin, Y.; Zhu, F.; et al. Analysis of the complete genome sequence of Paenibacillus sp. lzh-N1 reveals its antagonistic ability. BMC Genom. 2024, 25, 276. [Google Scholar] [CrossRef] [PubMed]
- Perry, E.B.; Valach, A.A.; Fenton, J.M.; Moore, G.E. An Assessment of Starch Content and Gelatinization in Traditional and Non-Traditional Dog Food Formulations. Animals 2022, 12, 3357. [Google Scholar] [CrossRef]
- Reese, A.T.; Chadaideh, K.S.; Diggins, C.E.; Schell, L.D.; Beckel, M.; Callahan, P.; Ryan, R.; Emery Thompson, M.; Carmody, R.N. Effects of domestication on the gut microbiota parallel those of human industrialization. eLife 2021, 10, e60197. [Google Scholar] [CrossRef]
- Lyu, T.; Liu, G.; Zhang, H.; Wang, L.; Zhou, S.; Dou, H.; Pang, B.; Sha, W.; Zhang, H. Changes in feeding habits promoted the differentiation of the composition and function of gut microbiotas between domestic dogs (Canis lupus familiaris) and gray wolves (Canis lupus). AMB Express 2018, 8, 123. [Google Scholar] [CrossRef]
- Xu, J.; Becker, A.A.M.J.; Luo, Y.; Zhang, W.; Ge, B.; Leng, C.; Wang, G.; Ding, L.; Wang, J.; Fu, X.; et al. The Fecal Microbiota of Dogs Switching to a Raw Diet Only Partially Converges to That of Wolves. Front. Microbiol. 2021, 12, 701439. [Google Scholar] [CrossRef]
- Chen, L.; Sun, M.; Xu, D.; Gao, Z.; Shi, Y.; Wang, S.; Zhou, Y. Gut microbiome of captive wolves is more similar to domestic dogs than wild wolves indicated by metagenomics study. Front. Microbiol. 2022, 13, 1027188. [Google Scholar] [CrossRef]
- Wang, G.; Chen, Y.; Xia, Y.; Song, X.; Ai, L. Characteristics of Probiotic Preparations and Their Applications. Foods 2022, 11, 2472. [Google Scholar] [CrossRef]
- Xia, J.; Cui, Y.; Guo, Y.; Liu, Y.; Deng, B.; Han, S. The Function of Probiotics and Prebiotics on Canine Intestinal Health and Their Evaluation Criteria. Microorganisms 2024, 12, 1248. [Google Scholar] [CrossRef]

| Gene Function | Number of Genes—ClWae17B | % of Total—ClWae17B | Number of Genes—ClWae19 | % of Total—ClWae19 |
|---|---|---|---|---|
| Cell cycle control, division, chromosome partitionin | 265 | 3.8 | 277 | 4.1 |
| Cell wall/membrane/envelope biogenesis | 374 | 5.4 | 368 | 5.4 |
| Cell motility | 92 | 1.3 | 104 | 1.5 |
| Post-translational modification, protein turnover, chaperones | 286 | 4.1 | 272 | 4.0 |
| Signal transduction mechanism | 492 | 7.1 | 512 | 7.5 |
| Intracellular trafficking, secretion, and vesicular transport | 99 | 1.4 | 102 | 1.5 |
| Defense mechanism | 230 | 3.3 | 245 | 3.6 |
| Extracellular structures | 42 | 0.6 | 46 | 0.7 |
| Nuclear structure | 0 | 0.0 | 0 | 0.0 |
| Cytoskeleton | 11 | 0.2 | 8 | 0.1 |
| RNA processing and modification | 1 | 0.0 | 0 | 0.0 |
| Chromatin structure and dynamics | 1 | 0.0 | 0 | 0.0 |
| Translation, ribosomal structure, and biogenesis | 379 | 5.5 | 359 | 5.3 |
| Transcription | 768 | 11.1 | 745 | 10.9 |
| Replication, recombination, and repair | 191 | 2.7 | 185 | 2.7 |
| Mobilome: prophages, transposons, | 100 | 1.4 | 127 | 1.9 |
| Energy production and conversion | 244 | 3.5 | 245 | 3.6 |
| Amino acid transport and metabolism | 440 | 6.3 | 415 | 6.1 |
| Nucleotide transport and metabolism | 173 | 2.5 | 162 | 2.4 |
| Carbohydrate transport and metabolism | 861 | 12.4 | 800 | 11.8 |
| Coenzyme transport and metabolism | 314 | 4.5 | 278 | 4.1 |
| Lipid transport and metabolism | 220 | 3.2 | 230 | 3.4 |
| Inorganic ion transport and metabolism | 346 | 5.0 | 343 | 5.0 |
| Secondary metabolites biosynthesis, transport, and metabolism | 106 | 1.5 | 106 | 1.6 |
| General function prediction only | 607 | 8.7 | 603 | 8.9 |
| Function unknown | 306 | 4.4 | 273 | 4.0 |
| Unclassified | 0 | 0.0 | 0 | 0.0 |
Disclaimer/Publisher’s Note: The statements, opinions and data contained in all publications are solely those of the individual author(s) and contributor(s) and not of MDPI and/or the editor(s). MDPI and/or the editor(s) disclaim responsibility for any injury to people or property resulting from any ideas, methods, instructions or products referred to in the content. |
© 2025 by the authors. Licensee MDPI, Basel, Switzerland. This article is an open access article distributed under the terms and conditions of the Creative Commons Attribution (CC BY) license (https://creativecommons.org/licenses/by/4.0/).
Share and Cite
Bryant, J.L.; McCabe, J.; Klews, C.C.; Johnson, M.; Atchley, A.N.; Cousins, T.W.; Barnard-Davidson, M.; Smith, K.M.; Ackermann, M.R.; Netherland, M., Jr.; et al. Phenotypic and Complete Reference Whole Genome Sequence Analyses of Two Paenibacillus spp. Isolates from a Gray Wolf (Canis lupus) Gastrointestinal Tract. Vet. Sci. 2025, 12, 51. https://doi.org/10.3390/vetsci12010051
Bryant JL, McCabe J, Klews CC, Johnson M, Atchley AN, Cousins TW, Barnard-Davidson M, Smith KM, Ackermann MR, Netherland M Jr., et al. Phenotypic and Complete Reference Whole Genome Sequence Analyses of Two Paenibacillus spp. Isolates from a Gray Wolf (Canis lupus) Gastrointestinal Tract. Veterinary Sciences. 2025; 12(1):51. https://doi.org/10.3390/vetsci12010051
Chicago/Turabian StyleBryant, Jessika L., Jennifer McCabe, C. Cristoph Klews, MiCayla Johnson, Ariel N. Atchley, Thomas W. Cousins, Maya Barnard-Davidson, Kristina M. Smith, Mark R. Ackermann, Michael Netherland, Jr., and et al. 2025. "Phenotypic and Complete Reference Whole Genome Sequence Analyses of Two Paenibacillus spp. Isolates from a Gray Wolf (Canis lupus) Gastrointestinal Tract" Veterinary Sciences 12, no. 1: 51. https://doi.org/10.3390/vetsci12010051
APA StyleBryant, J. L., McCabe, J., Klews, C. C., Johnson, M., Atchley, A. N., Cousins, T. W., Barnard-Davidson, M., Smith, K. M., Ackermann, M. R., Netherland, M., Jr., Hasan, N. A., Jordan, P. A., Forsythe, E. S., Ball, P. N., & Seal, B. S. (2025). Phenotypic and Complete Reference Whole Genome Sequence Analyses of Two Paenibacillus spp. Isolates from a Gray Wolf (Canis lupus) Gastrointestinal Tract. Veterinary Sciences, 12(1), 51. https://doi.org/10.3390/vetsci12010051

